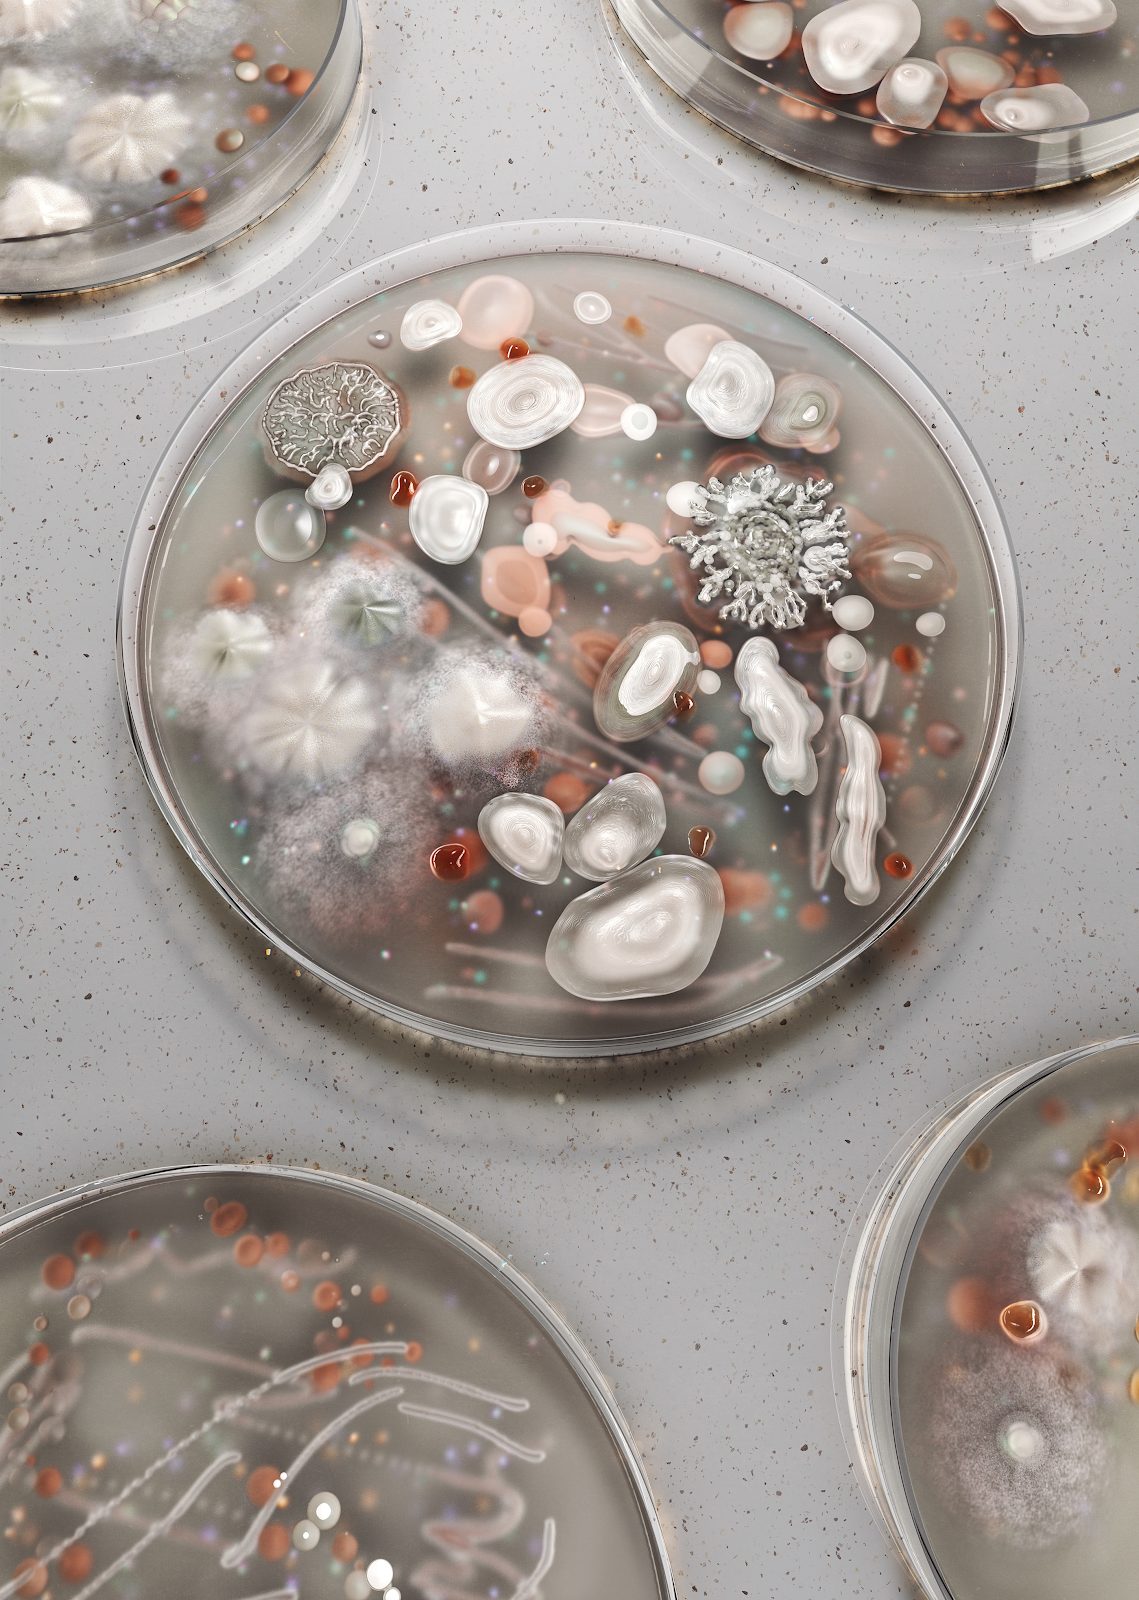
mejor-diseno-grafico-2021-hemaware-magazine-08

Un año más llega el momento en el que hacemos balance y hablamos de los mejores diseños gráficos de 2020 – 2021.
Si os gusta nuestro contenido os invito a suscribiros a nuestra newsletter y así recibiréis nuestros nuevos artículos y no os perderéis nada, todo muy cómodo en la bandeja de entrada.
Inscribirse a la newsletter Suscríbete ahora
Como el año anterior tuvo tanto éxito esta nueva serie, repetimos otra vez.
[superfeatured]7076[/superfeatured]
La selección de trabajos que mostramos en este artículo es totalmente personal y para ella hemos hecho un trabajo a fondo buceando en las mejores páginas web del planeta, los mejores estudios de diseño gráfico.
Hemos recogido un total de 20 trabajos de diseño gráfico comentados en profundidad, todo esto para vuestra inspiración.
¡Sin más, empezamos con ello!
Empezamos este paseo por los mejores diseños gráficos del 2020 y 2021 con el proyecto que el estudio de diseño gráfico y creatividad Seachange Studio ha realizado para Silo Theatre.
Silo Theatre es uno de los referentes de teatro y arte contemporáneo.
El proyecto forma parte de la creación de la campaña de 2020 para el Silo y ha sido premiada con 3 premios Best Design Awards del Designers Institute of New Zealand
En el proyecto destacamos el uso de colores muy vivos y potentes con mucho contraste y de imágenes muy frescas en el que el color se superpone a las imágenes y a través de las formas creadas con las formas y colores.
El resultado es un producto con una factura perfecta que transmite la frescura y la vanguardia del proyecto, que, sin duda, es un referente de de creatividad y del uso de tendencias en diseño gráfico para 2021.

Otra de las tendencias en diseño gráfico de 2021 es la ilustración semi-realista o lo que es lo mismo dibujos con aspecto fotográfico o fotografías con aspecto de ilustración.
En este sentido el artista Kurt Chang es un genio como podemos ver en su proyecto de ilustración semi-realista.
Su trabajo destaca por el uso de colores y de formas muy naturales, que transmiten sensaciones de cercanía, costumbrismo y mucha suavidad.
Nos llama la atención que en sus ilustraciones hay componentes actuales combinados con elementos futuristas que hacen el conjunto perfecto.
Dadle un vistazo a su página web repasad su trabajo, sin duda un ejemplo de las tendencias en diseño gráfico para 2021 y uno de los mejores trabajos en diseño gráfico de 2021.

Esta es una de las referencias preferidas del artículo.
El proyecto forma parte de la campaña que Ben J. Crick ha realizado para Spotify y tiene un montón de recursos que lo hacen espectacular.
El conjunto del proyecto tiene:
Ben J. Crick : ” Ben Crick says. “I think that’s the beauty of it. Working at that scale, if you can build a system that enables people to do good work, it becomes much bigger than any individual.”
Este proyecto, sin duda, es muy innovador y se nota que la empresa Spotify, dedicada al mundo de la música online, no tiene ningún tipo de complejo ni freno a la hora de encargar una campaña de identidad visual anual.

Diametralmente opuesto a los proyectos anteriores y no por eso menos interesantes, aparece en este listado el diseño de packaging del arroz Srisangdao que el estudio de diseño gráfico y branding Prompt Design ha realizado.
Thung Kula Ronghai es una marca de arroz muy conocida en Tailandia por ofrecer un producto de calidad y prueba de ello es que su producción anual está limitada al impacto en el medio ambiente. Además es un producto completamente orgánico y libre de químicos.
En este sentido el packaging tenía el reto de reflejar estas premisas y se ha diseñado usando materiales completamente reciclables.
En el apartado de diseño destacamos que la caja tiene la forma troquelada de un grano de arroz y el arroz viene en un pequeño saquito con la numeración impresa.
Este proyecto ha sido premiado, entre otros con:
Un proyecto muy innovador que cuenta con algunas de las tendencias en diseño gráfico de 2021.





El diseño del packaging de Milton Chocolate es otra de las genialidades del diseño gráfico y la creatividad.
Miltos propone un chocolate que va más allá del concepto infantil del producto, alejando el producto de la imagen de azúcar para niños y llevándolo a un público más adulto.
El paquete expresa el aroma del cacao por la textura de la tela de seda, como si de una escultura se tratara.
El estuche, en forma de libro, se abre por la tapa, y tiene adjunta una tarjeta con la tabla de sabores.
La caja de surtido se diseño a partir de la imagen de una estantería.
En el apartado de producción, el paquete utiliza papel fino azul oscuro, turquesa para expresar el sabor a chocolate negro y brilla en diferentes tonalidades.
Está estampado en láminas de oro y después está troquelado y unido.
El resultado es una experiencia de marca espectacular que ha sido premiada, entre otros con el:
Una referencia que puede inspirar a todos los creativos de proyectos de lujo.

[superfeatured]7076[/superfeatured]
El Festival de los teatros de calle «la cuarta pared» basa el diseño de su campaña gráfica en la idea que la cuarta pared son las paredes de la calle y el escenario está formado por un trapecio que cambia de ángulo en función del lugar donde se sienta el espectador.
El estilo del diseño gráfico es dinámico y representa perfectamente el arte de la danza contemporánea.
El proyecto destaca por el uso de imágenes de bailarin@s con formas superpuestas y combinación de colores y el blanco y negro.
Una mezcla clásica y vanguardista que la hace una muestra perfecta y la referencia ideal para este listado de los mejores diseños gráficos de 2021 que servirá de inspiración a futuros proyectos.

Markus Kay es un artista visual con base en Londres y es el creador de esta fantástica serie de ilustraciones de carácter científico que se han publicado en el magazine Hemaware y que tiene el objetivo de hacer coger consciencia sobre las patologías de la sangre, los nuevos tratamientos y los estudios y búsquedas de tratamientos.
El estilo destaca por el uso de la paleta de colores que son sutiles que se alejan de la imagen de miedo que este tipo de temas tiene intrínsecos.
El proyecto a sido premiado con muchos galardones relacionados con el diseño y la creatividad en el mundo de las publicaciones científicas y médicas.
Este proyecto es un obra maestra, absolutamente asombrosa e impresionante. Con una concepción original e innovadora en su ejecución.
El proyecto conecta auténtica y combina eso con una ejecución visual fresca y actual que tiene en cuenta las tendencias de diseño gráfico de 2021.
Proyecto premiado con:
Atención al uso de color y forma abstracta.

Un proyecto que entra directamente en este listado en el que repasamos los mejores diseños gráficos para 2021 por su carácter innovador y creativo.
El diseño de las etiquetas de Neon Jungle destaca por su colorido y su atractivo diseño que es anticipa a las que van a ser las tendencias en diseño gráfico de 2021.

Para reforzar la tendencia en diseño gráfico y de producción del empleo de troquelados y bajorrelieves os traigo este ejemplo de proyecto.
La marca Brite es una marca exclusiva de materiales de revestimiento para superficies de madera y el objetivo de la agencia de branding era crear un diseño que ayudara al consumidor a elegir el producto concreto y, a la par, resaltar la pasión de la marca por la madera.
Cada SKU tiene su tipografía particular de estilo hiperdecorativo y que se convierte en identidad de producto.

El objetivo que el estudio de diseño y comunicación Oneforall tenía era comunicar un toque moderno en elementos asociados con los sectores comerciales e industriales.
El diseño de la identidad y comunicación visual es muy elegante, tiene elementos en bajorrelieve y una combinación de colores en negro y naranja.
El proyecto ha sido un proyecto finalista en la categoría de diseño y comunicación del Designers Institute of New Zealand.

Con un enfoque totalmente clásico de envase inspirado en la reputación de compañero de viaje del vino para los grandes pensadores y filósofos griegos el vino se embotella en ánforas tradicionales y se envuelve en un sudario de papel con un representación clásica, cercana y personal de una estatua griega.
El proyecto destaca por su conceptualización clásica y su producción totalmente personal en la que destacan las grandes tipografías «monster typos» y el bajorrelieve de la botella.
Sin duda una fuente de inspiración perfecta para los proyectos de packaging y creación de marca para el 2021.

El ilustrador Zimmer Design es el encargado de regalarnos el diseño de la nueva imagen de marca de café Coffee Cold.
El proyecto basa su valor en las etiquetas retro-futuristas de aire psicodélicas únicas, visualmente llamativas y geniales.
El objetivo era diferencias su producto del resto de la competencia y hacerlo único en su sector alejándolo de la típica imagen monocromática de las marcas de café.


[superfeatured]7076[/superfeatured]
Este diseño corresponde a la edición limitada Very Special de la marca y que el artista Felipe Pantone de Apartment 103 ha realizado.
Es una obra de diseño exclusiva con un punto de vista muy audaz en el que las formas abstractas y geométricas tiene gran parte del peso del diseño.
Un diseño llamativo que eleva la marca a través de una oferta contemporánea e hipnótica.
Con colores vibrantes, relieves y juegos contrastantes de acabado mate y barniz que transmite una de las experiencias más atrevidas de una marca icónica de Cognac en todo el mundo.

Un proyecto de diseño gráfico e impresión de objetos del estudio de diseño gráfico Beetroot Design Group.
Destacamos el uso de tipografías grandes, diferentes, personales, creadas para la ocasión y que forman parte del diseño de los elementos y del packaging de los productos.
El proyecto a ganado el EDAwards en la categoría de Printed Miscellaneous.
No os perdáis las imágenes con las que detallamos el proyecto y tomad nota sobre esta tendencia en diseño gráfico de 2021.

El estudio de diseño gráfico y creación de branding NB Studio ha sido el encargado de ayudar a Bankside a fortalecer las asociaciones de visitantes entre el área y su nombre.
La campaña iba encaminada a mostrar una imagen impulsada por el nombre al posicionar a Bankside como el otro lado de Londres.
Se creó un sistema creativo que impulsó el nombre de Bankside y incluyó un breve escrito creativo de la marca.
Perfecta fuente de inspiración para tus proyectos de diseño gráfico que cuenta con algunas de las tendencias en diseño gráfico de 2021 que vienen con fuerza.

El estudio de diseño gráfico independiente One Design de Nueva Zelanda nos trae este diseño de packaging y botella de Ginebra.
Este proyecto ha sido premiado por el Designers Institute of New Zealand con un:
Como se puede observar en la botella y en las imágenes de esta referencia se ha utilizado elementos marinos como el esqueleto de un erizo de mar que ofrece la sujeción y la sensación que pasa de la botella al consumidor.
Un proyecto que os puede servir de inspiración en diseño gráfico de packaging y creatividad para vuestros proyectos de 2021.

Se trata de un libro ilustrado de poesía moderna de la autora Mariana Savka.
Las ilustraciones están impresas en dos colores: azul y rojo, y el lector puede mirar la imagen a simple vista y/o a través de del filtro rojo adjunto al libro para que la imagen cambie.
Con el filtro podemos ver objetos y formas escondidas en la ilustración original y se abre un diálogo entre el creador y el lector.
El proyecto es un toque de atención del uso de filtros en la redes sociales, en la vida real y en definitiva con la realidad.
Con esta idea exploramos las dos caras de una misma moneda que forman un todo absoluto.
El proyecto ha sido premiado con:
Buena fuente de inspiración y final del artículo.




[superfeatured]7076[/superfeatured]
Como vemos el año 2021 vamos a ver diseños muy atrevidos, con colores muy vivos y mucha tipografía. Realmente los artistas del lettering tienen que estar muy contentos porque ya hace un par de años que, por fin, han llegado al mainstream del diseño gráfico.
No os perdáis el artículo que estamos cociendo sobre tendencias en diseño gráfico para 2021, yo ya he visto algo y es espectacular.
Analizamos tu situación actual y definimos el siguiente paso.
Contacta ahoraRevisaremos tu situación digital actual. Nos pondremos en contacto contigo para entender tu contexto y valorar conjuntamente qué áreas analizar, y posteriormente elaboraremos una auditoría con los puntos clave y recomendaciones.